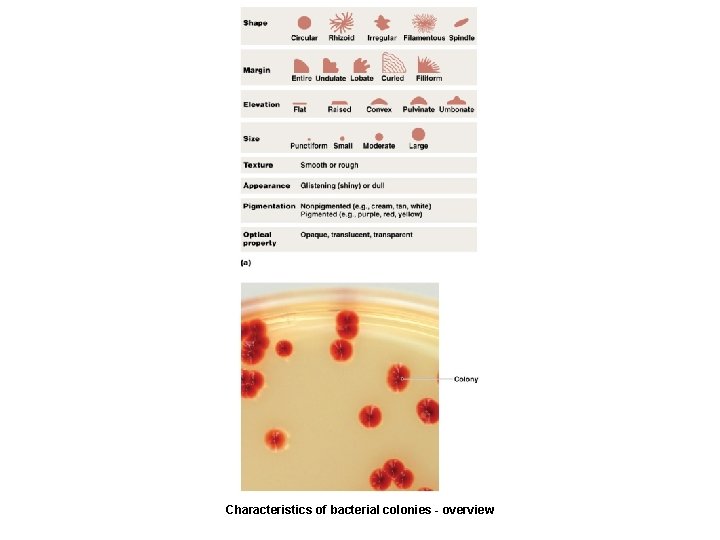
Characteristics of bacterial colonies - overview
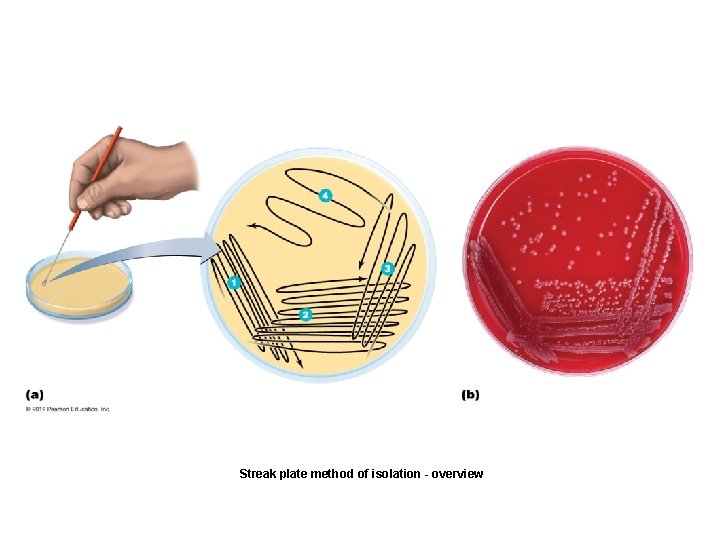
Streak plate method of isolation - overview
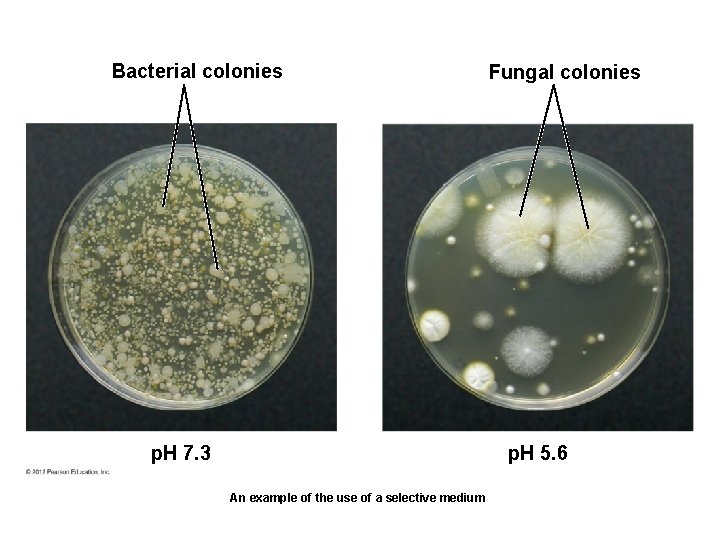
Bacterial colonies p. H 7. 3 Fungal colonies p. H 5. 6 An example
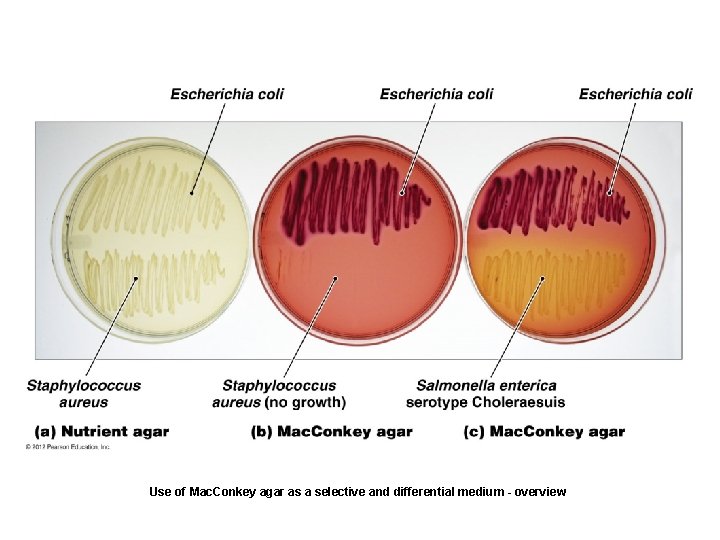
Use of Mac. Conkey agar as a selective and differential medium - overview

MICROBIAL NUTRITION GROWTH Growth Requirements Microbial growth Increase

MICROBIAL NUTRITION & GROWTH

Growth Requirements • Microbial growth – Increase in a population of microbes • Result of microbial growth is discrete colony – An aggregation of cells arising from single parent cell • Reproduction results in growth

Growth Requirements • Organisms use a variety of nutrients for their energy needs and to build organic molecules and cellular structures • Most common nutrients contain necessary elements such as carbon, oxygen, nitrogen, and hydrogen • Microbes obtain nutrients from variety of sources

Growth Requirements LEARNING OBJECTIVES • Describe the roles of carbon, hydrogen, oxygen, nitrogen , trace elements, and, vitamins in microbial growth and reproduction • Compare the four basic categories of organisms based on their carbon and energy sours • Distinguish among anaerobes, and microaerophiles • Explain how oxygen can be fatal to organisms by discussinglet oxygen, superoxide radical, peroxide anion, and hydroxyl, radical and describe how organisms protect themselves from toxic from of oxygen • Defined nitrogen fixation and explain its importance • Nutrients: Chemical and Energy Requirements – Sources of carbon, energy, and electrons – Two groups of organisms based on source of carbon – Autotrophs – Heterotrophs – Two groups of organisms based on source of energy – Chemotrophs – Phototrophs

Four basic groups of organisms

Growth Requirements • Nutrients: Chemical and Energy Requirements – Oxygen requirements – Oxygen is essential for obligate aerobes – Oxygen is deadly for obligate anaerobes – How can this be true? – Toxic forms of oxygen are highly reactive and excellent oxidizing agents – Resulting oxidation causes irreparable damage to cells

Growth Requirements • Nutrients: Chemical and Energy Requirements – Oxygen requirements – Four toxic forms of oxygen – Singlet oxygen – Superoxide radicals – Peroxide anion – Hydroxyl radical

Catalase test

Growth Requirements • Nutrients: Chemical and Energy Requirements – Oxygen requirements – Aerobes – Anaerobes – Facultative anaerobes – Aerotolerant anaerobes – Microaerophiles

Oxygen requirements of organisms - overview

Growth Requirements • Nutrients: Chemical and Energy Requirements – Nitrogen requirements – Anabolism often ceases because of insufficient nitrogen – Nitrogen acquired from organic and inorganic nutrients – All cells recycle nitrogen from amino acids and nucleotides – Nitrogen fixation by certain bacteria is essential to life on Earth

Growth Requirements • Nutrients: Chemical and Energy Requirements – Other chemical requirements – Phosphorus – Sulfur – Trace elements – Required only in small amounts – Growth factors – Necessary organic chemicals that cannot be synthesized by certain organisms

Growth Requirements LEARNING OBJECTIVE • Explain how extremes of temperature, p. H, and osmotic and hydrostatic pressure limit microbial growth • Physical Requirements – Temperature – Effect of temperature on proteins – Effect of temperature on membranes of cells and organelles – If too low, membranes become rigid and fragile – If too high, membranes become too fluid

Microbial growth - overview

Growth rate Thermophiles Mesophiles Hyperthermophiles Psychrophiles Temperature (°C) Four categories of microbes based on temperature ranges for growth

An example of psychrophile - overview

Growth Requirements • Physical Requirements – p. H – Organisms are sensitive to changes in acidity – H+ and OH– interfere with H bonding – Neutrophiles grow best in a narrow range around neutral p. H – Acidophiles grow best in acidic habitats – Alkalinophiles live in alkaline soils and water

Growth Requirements • Physical Requirements – Physical effects of water – Microbes require water to dissolve enzymes and nutrients – Water is important reactant in many metabolic reactions – Most cells die in absence of water – Some have cell walls that retain water – Endospores and cysts cease most metabolic activity – Two physical effects of water – Osmotic pressure – Hydrostatic pressure

Growth Requirements • Physical Requirements – Physical effects of water – Osmotic pressure – Pressure exerted on a semipermeable membrane by a solution containing solutes that cannot freely cross membrane – Hypotonic solutions have lower solute concentrations – Hypertonic solutions have greater solute concentrations – Restricts organisms to certain environments – Obligate and facultative halophiles

Growth Requirements • Physical Requirements – Physical effects of water – Hydrostatic pressure – Water exerts pressure in proportion to its depth – Barophiles live under extreme pressure – Their membranes and enzymes depend on pressure to maintain their shape

Growth Requirements LEARNING OBJECTIVE • Describe how quorum sensing can lead to formation. • Associations and Biofilms – Organisms live in association with different species – Antagonistic relationships – Synergistic relationships – Symbiotic relationships

Growth Requirements • Associations and Biofilms – Complex relationships among numerous microorganisms – Develop an extracellular matrix – Adheres cells to one another – Allows attachment to a substrate – Sequesters nutrients – May protect individuals in the biofilm – Form on surfaces often as a result of quorum sensing – Many microorganisms more harmful as part of a biofilm

Plaque (biofilm) on a human tooth

Culturing Microorganisms • Inoculum introduced into medium – Environmental specimens – Clinical specimens – Stored specimens • Culture – Act of cultivating microorganisms or the microorganisms that are cultivated
Characteristics of bacterial colonies - overview

Culturing Microorganisms LEARNING OBJECTIVE • Describe the two most common methods by which microorganisms can be isolated for culture. • Obtaining Pure Cultures – Cultures composed of cells arising from a single progenitor – Progenitor is termed a CFU – Aseptic technique prevents contamination of sterile substances or objects – Two common isolation techniques – Streak plates – Pour plates
Streak plate method of isolation - overview

Pour plate method of isolation - overview

Culturing Microorganisms LEARNING OBJECTIVE • Describe six types of general culture media available for bacterial culture • Culture Media – Majority of prokaryotes have not been grown in culture medium – Six types of general culture media – Defined media – Complex media – Selective media – Differential media – Anaerobic media – Transport media

Slant Butt Slant tube containing solid media
Bacterial colonies p. H 7. 3 Fungal colonies p. H 5. 6 An example of the use of a selective medium

Beta-hemolysis Alpha-hemolysis No hemolysis (gamme-hemolysis) The use of blood agar as a differential medium

Durham tube (inverted Tube to trap gas) No fermentation Acid fermentation with gas The use of carbohydrate utilization tubes as differential media
Use of Mac. Conkey agar as a selective and differential medium - overview

Clamp Airtight lid Palladium pellets to catalyze reaction removing O 2 Chamber Envelope containing chemicals to release CO 2 and H 2 Methylene blue (anaerobic indicator) Petri plates An anaerobic culture system

Culturing Microorganisms LEARNING OBJECTIVE • Discuss the use of special culture methods including animal and cell culture, low-oxygen culture, and enrichment culture • Special Culture Techniques – Techniques developed for culturing microorganisms – Animal and cell culture – Low-oxygen culture – Enrichment culture

Culturing Microorganisms LEARNING OBJECTIVE • Contrast refrigeration, deep freezing, and lyophilization as methods for preserving culture of microbes • Preserving Cultures – Refrigeration – Stores for short periods of time – Deep-freezing – Stores for years – Lyophilization – Stores for decades

Binary fission events - overview

Comparison of arithmetic and logarithmic growth - overview

Growth of Microbial Populations LEARNING OBJECTIVE • Explain what is meant by the generation time op bacteria • Generation Time – Time required for a bacterial cell to grow and divide – Dependent on chemical and physical conditions

Two growth curves of logarithmic growth - overview

Number of live cells (log) Stationary phase Log (exponential) phase Lag phase Time Typical microbial growth curve Death (decline) phase

Fresh medium with a limiting amount of a nutrient Flow-rate regulator Sterile air of other gas Culture vessel Culture Overflow tube Schematic of chemostat

Growth of Microbial Populations • Measuring Microbial Reproduction – Direct methods – Serial dilution and viable plate counts – Membrane filtration – Most probable number – Microscopic counts – Electronic counters

Estimating microbial population size - overview

Use of membrane filtration to estimate microbial population - overview

1. 0 ml Undiluted 1. 0 ml 1: 100 Inoculate 1. 0 ml into each of 5 tubes Phenol red, p. H color indicator, added Incubate Results 4 tubes positive 2 tubes positive 1 tube positive The most probable number (MPN) method for estimating microbial numbers

The use of a cell counter for estimating microbial numbers - overview

Growth of Microbial Populations LEARNING OBJECTIVE • Contrast direct and indirect methods of measuring bacterial • Measuring Microbial Growth – Indirect methods – Metabolic activity – Dry weight – Turbidity

Spectrophotometry - overview

Growth of Microbial Populations • Measuring Microbial Reproduction – Genetic methods – Isolate DNA sequences of unculturable prokaryotes – Used to estimate the number of these microbes
- Slides: 51